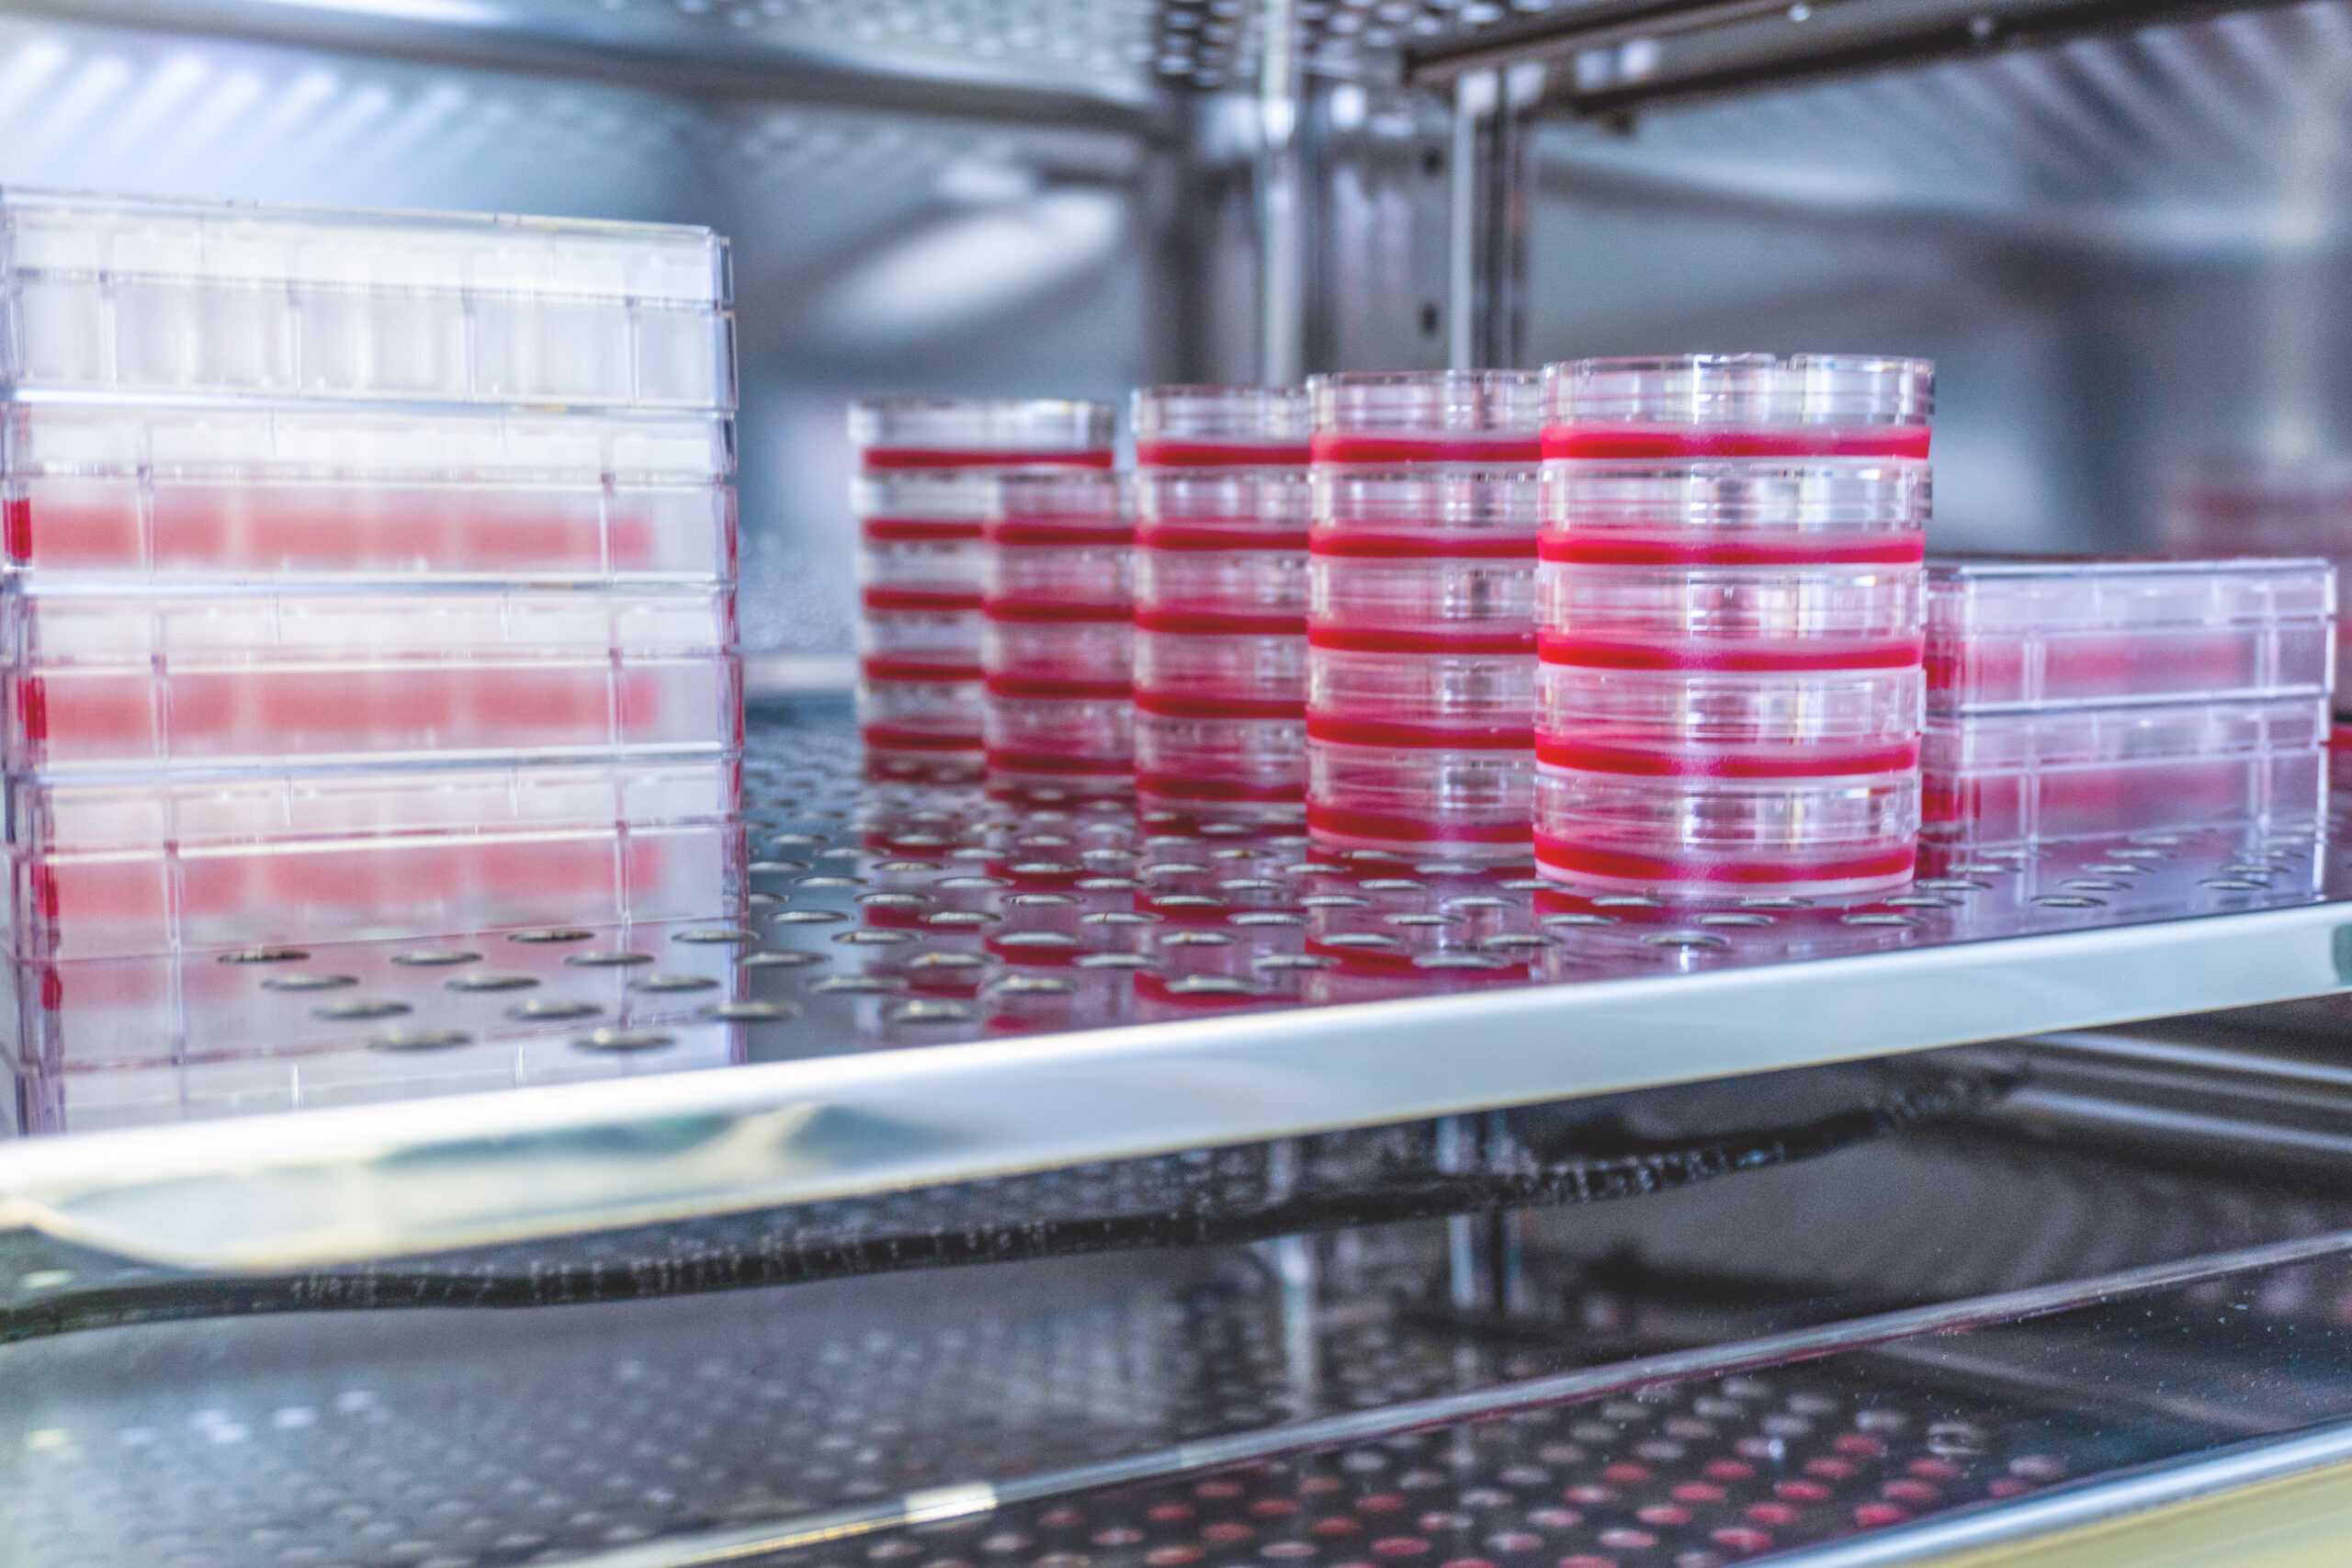

理念・ミッション・ビジョン
企業理念
リプロセルは次世代医療を通じ人々の健康福祉に貢献することを目指しています
株式会社リプロセル
reprocell.co.jp
企業概要
| 社名 | 株式会社リプロセル |
| フリガナ | リプロセル |
| WEBサイト | https://reprocell.co.jp/ |
| 設立年月日 | 2003年2月 |
| 理念・ミッション | ■企業理念 リプロセルは次世代医療を通じ人々の健康福祉に貢献することを目指しています |
| 事業内容 | ①研究支援事業 ・iPS細胞関連研究試薬の製造・販売 ・創薬支援サービスの提供(iPS細胞の樹立、CROサービスなど) ・生体試料の提供 ・遺伝子解析サービスの提供 ②メディカル事業 ・臨床検査の受託サービス ・再生医療等製品の開発 |
| 資本金 | 17億1,500万円 |
関連情報
ご注意: 本サイトで提供する情報は、第三者の視点から抽出したものであり、元の情報が変更されている場合や、元の情報と若干の相違がある可能性がございます。その点をご理解いただき、ご利用いただけますようお願い申し上げます。
企業ご担当者さま
情報の追加修正、削除依頼、その他採用に関するお知らせやプレスリリースの掲載などの
ご希望がございましたらこちらよりお問い合わせください。
企業担当者さま
情報の追加修正、削除依頼、
その他採用に関するお知らせや
プレスリリースの掲載などの
ご希望がございましたらこちら
よりお問い合わせください。
ストーリー:TeamTale
御社のストーリーを理念会議に掲載しませんか?
